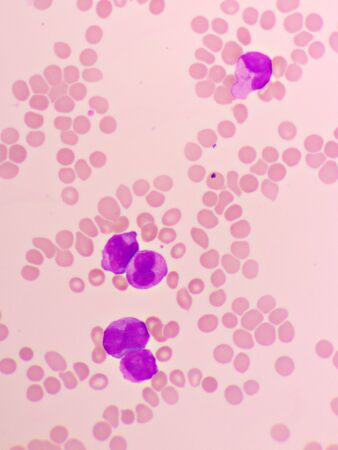
Acute promyelocytic leukemia cells or APLの写真素材

写真素材 - Acute promyelocytic leukemia cells or APL
キーワード
- ALL
- AML
- APL
- CBC
- CLL
- CML
- Neutrophil
- abnormal
- acute
- analyzing
- blast
- blood
- bone
- cancer
- care
- cell
- chronic
- complete
- count
- disease
- exam
- film
- health
- hematology
- hematopoiesis
- laboratory
- leukemia
- leukocyte
- lymphoblast
- lymphoblastic
- lymphocyte
- lymphocytic
- marrow
- medical
- microscope
- monocyte
- myeloblast
- myeloblastic
- platelet
- promyeloblast
- promyelocytic
- red
- research
- science
- slide
- smear
- test
- white
類似作品
The view showca...
Healthy human r...
Abnormal red bl...
Bath sponge tex...
This digital il...
Leukocyte cells...
The vibrant ima...
Soap bubbles wi...
3D illustration...
A dark golden c...
Blast cells in ...
Coronavirus out...
a close up of r...
Red background ...
Veillonella bac...
Electron micros...
Drops on window...
Human cells of ...
Cancer Cell in ...
Healthy human r...
Bacteria Franci...
blood cells
Acute promyeloc...
Atypical, or re...
Microscopic Vie...
Iron deficiency...
Abstract colorf...
White blood cel...
Neutrophil cell...
Chronic myeloid...
Blood cells wit...
Blood smear
Round shape bot...
Red spots and b...
body fluid
3d rendering of...
Purple Rusty Ba...
White blood cel...
Sperm and egg c...
Immature and ma...
close-up of ste...
Cancer Cell in ...
Vivid Microscop...
Abstract backgr...
Abstract fluid ...
Microbial life ...
The malaria-inf...